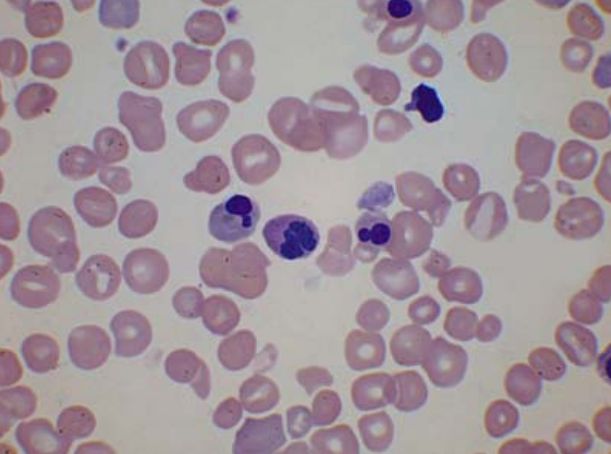

7BM019 Advanced Haematology Assessment
- Subject Code :
7BM019
You will be able to consult notes, textbooks, published articles, and your answers will be marked accordingly. Turnitin or other text-matching software may be used to check for plagiarism or collusion. The answers you submit must be your own work.
You will not be expected to show evidence of research except for section C, where reference sources must be acknowledged using Harvard referencing. A maximum of four references should be used.
A maximum limit of 400 words for each question in section A, and 800 words each for sections B and C, applies.
Section A Data interpretation
Answer all questions. Each question in this section is worth 10 marks.
Question 1
Chromatogram

The chromatogram and blood indices (with reference ranges) shown above were taken from a 20-year old South Indian male patient who was awaiting surgery.
From what haemoglobinopathy is this patient likely to be suffering? Justify your diagnosis.
Question 2
A 26-year-old man reported to the Accident and Emergency Department complaining of chest pain in his right side and blood in his sputum. He had a history of deep vein thrombosis, and had been treated a few years ago for a thrombus in his left leg. His sister had also suffered DVT during a pregnancy.
He was prescribed low molecular weight heparin and warfarin, but ten days later reported a swelling in his right leg. Ultrasonography showed several acute thromboses in his right leg, lower vena cava and pulmonary embolism in the lower right lung. The following assays were carried out:

He was treated with further anticoagulant therapy until the D-dimer levels reverted to normal.
Explain the likely mechanism of the thrombotic tendency in this patient.
Question 3
A blood film is shown below for a two-day old neonate with persisting jaundice. The baby is found to be severely anaemic.
Describe the features of the blood film. Suggest a possible diagnosis, and explain how the salient features fit this diagnosis.
Question 4
A patient who is typed as group A Rh(D) negative requires a red cell transfusion and was found to have antibodies in her plasma that reacted with cells of the two-cell screening panel, so a full ten-cell panel was tested to try to find the specificity of the antibody or antibodies. The results are shown in the table below (+ = agglutination, - = no reaction).

What is the likely specificity of the antibody or antibodies? Explain how you exclude the possibility of further antibodies, and any confirmatory tests you need to do before ordering red cells. What red cell units should you request for the patient?
Section B - Comprehension
Choose one question from this section. Each question in this section is worth 20 marks.
- Read the following summary of the paper of Berthet et al., Clinical Immunology 2012; 145:189-200 and answer the following questions:
The authors were investigating how platelets and peripheral blood mononuclear cells (monocytes and lymphocytes, PBMCs) can influence each others response to bacterial LPS. Platelets are known to express Toll-like receptors (TLR4) and monocytes CD14, both of which bind LPS.
They isolated platelets and PBMCs from blood donated by healthy volunteers. They incubated platelet-rich plasma for 30 minutes with either PBS (negative control), thrombin-related activator peptide (TRAP, a powerful thrombin-mimetic, to activate the platelets) or S-LPS from E. coli or R-LPS from S. minnesota, then incubated monocytes with supernatants from the platelets for 24 hours in culture. Figure 5 shows the release of three cytokines, measured by ELISA, from these PBMCs.
Explain in your own words how they designed this experiment to demonstrate the essential role of platelets in cytokine production from monocytes in this experiment. (Note that the grid at the bottom of the figure showing which reagents were added does not line up perfectly with the rest of the figure. PHA / IL-2 is not explained anywhere in the paper, but is presumably a positive control that will directly stimulate monocytes. PHA is probably a similar compound to 12-phorbol 13-myristate acetate.) - Read the paper by Razmkhah et al. Tumor Biology 2017;1-8, DOI: 10.1177/1010428317692234 and the summary below, and answer the following questions:
The investigators obtained bone marrow samples from AML patients (at diagnosis, before initiation of treatment) and healthy BM donors. Nucleated cells were grown in culture, then frozen at -20C. After thawing, microvesicles were isolated in PBS from these cultures by ultracentrifugation.
Haemopoietic stem cells (HSCs) were isolated from cord blood by density gradient centrifugation and sorting using anti-CD34 coupled to magnetic beads. They were seeded into microwells at equal cell density in a suitable growth medium with growth factor supplements, and incubated for seven days with either PBS (control), healthy marrow-derived microvesicles or leukaemic marrow-derived microvesicles.
The following tests were carried out on the resulting cells.
- They were transferred to a haemocytometer for counting of viable cells.
- They were stained with fluorescent-labelled antibodies against stem cell markers for cytometric analysis.
- They were grown further in culture to assess differentiation into colony forming units (CFUs) of different lineages.
- RNA was extracted and converted to cDNA copies of miRNA-21 and miRNA-29a by real-time PCR. Quantification of mRNA was assessed by comparison to small nucleolar RNA (Snord 47).
In a short paragraph of your own words, summarize the findings of the study and their significance.
Section C - Essays
Choose one question from this section. Each question in this section is worth 20 marks.
- In view of the new model of in vivo blood coagulation proposed by Hoffman and Monroe, explain why severe deficiency of FXI confers a mild bleeding tendency, but severe deficiency of FVIII a much more serious diathesis. Cite two suitable scientific papers to support your answer.
- With reference to two peer-reviewed scientific sources, explain what is meant by minimum residual disease (MRD). How and why is it measured in patients with leukaemia?
Are you struggling to keep up with the demands of your academic journey? Don't worry, we've got your back! Exam Question Bank is your trusted partner in achieving academic excellence for all kind of technical and non-technical subjects.
Our comprehensive range of academic services is designed to cater to students at every level. Whether you're a high school student, a college undergraduate, or pursuing advanced studies, we have the expertise and resources to support you.
To connect with expert and ask your query click here Exam Question Bank